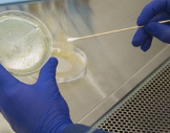

FOCUS ON
Formazione obbligatoria
per la sicurezza sul lavoro
Una garanzia per la salute dei lavoratori e dei pazienti
HC Training
viale Bruno Rizzieri, 226 00173 Roma (RM)
tel. 06 72480500 fax 06 7224482
Azienda Umberto I Policlinico di Roma
viale del Policlinico, 155 00161 Roma (RM)
tel. 06 49971
|

ForumECM in questo numero punta la sua attenzione sulla formazione obbligatoria in materia di tutela della salute e sicurezza negli ambienti ospedalieri.
Una formazione, questa, che deve essere garantita dall’azienda sanitaria e che coinvolge diverse figure professionali che vanno dal semplice lavoratore (medico, infermiere, biologo, ostetrica etc.) a chi svolge, per la carica che ricopre, anche un ruolo di responsabilità gestionale ed organizzativa, come nel caso del Datore di Lavoro, ovvero il Direttore Generale dell’Azienda, del Dirigente e del Preposto.
Questo è quanto stabilito nell’Accordo tra il Ministro del Lavoro e delle Politiche Sociali, il Ministro della Salute, le Regioni e le Province autonome di Trento e Bolzano per la formazione dei lavoratori ai sensi dell’articolo 37, comma 2, del decreto legislativo del 9 aprile 2008, n. 81.
La gestione di una struttura ospedaliera, di per sé molto complessa in relazione alla specificità dei singoli pazienti e degli interventi, alla varietà dei processi gestionali e non per ultimo alla molteplicità di operatori impegnati in diverse attività sanitarie, pone notevoli problematiche non solo organizzative, ma anche relative alla sicurezza e alla prevenzione a tutela dei pazienti, dei lavoratori e dell’ambiente.
Gli ospedali, sono o dovrebbero essere per definizione, i luoghi dove la salute e la sicurezza raggiungono i massimi livelli di attuazione. In ogni ospedale dovrebbe esistere un sistema di gestione della sicurezza, basata su una continua ricerca di soluzioni sempre più avanzate ed efficaci e soprattutto su un corretto operato da parte dei lavoratori. Per garantire tutto questo è necessario che ogni operatore, qualsiasi sia la sua mansione, conosca alla perfezione i rischi legati alla propria attività ed agisca di conseguenza nel pieno rispetto delle leggi.
Nel caso specifico delle aziende sanitarie, nonostante chi vi lavori abbia già un alto grado di sensibilizzazione e spesso di preparazione su temi inerenti la salute e la sicurezza, derivata dal percorso formativo delle Scuole Professionali o delle Scuole di Specializzazione, è comunque necessario ed obbligatorio da parte dell’azienda assicurare una formazione completa ed un continuo aggiornamento del personale.
Nei corsi di formazione che le aziende sanitarie sono tenute ad organizzare, devono essere affrontati i concetti di rischio, danno, prevenzione, protezione, organizzazione della prevenzione aziendale, diritti e doveri dei vari soggetti aziendali, organi di vigilanza, controllo ed assistenza. Inoltre devono essere trattati argomenti relativi ai rischi riferiti alle specifiche mansioni, ai possibili danni ed alle conseguenti misure e procedure di prevenzione e protezione caratteristici del settore o comparto di appartenenza dell’azienda.
Così come previsto dal D.Lgs. n. 81 del 2008 e s.m.i., alla data del 26 gennaio 2012 sono entrati in vigore inoltre due nuovi accordi per la formazione dei Datori di Lavoro che svolgono direttamente i compiti di prevenzione e protezione (DLSPP), dei Lavoratori, dei Preposti e dei Dirigenti.
In questi accordi, dove vengono stabilite le modalità di erogazione dei corsi di formazione sulla sicurezza, sono individuate inoltre tre macrocategorie di attività lavorative: quelle a rischio basso, medio ed alto, ed è proprio in quest’ultima rientra il settore sanitario.
Formazione per i datori di lavoro
In passato, per i DLSPP, era sufficiente frequentare un corso di 16 ore, indifferentemente per qualsiasi attività.
Oggi invece, il nuovo Accordo apporta delle modifiche introducendo non solo un percorso formativo differenziato a seconda dell’attività del lavoratore e della macrocategoria di rischio a cui appartiene, ma anche l’obbligatorietà all’aggiornamento.
Infatti, la macrocategoria di rischio alto, dove rientra il settore sanitario, prevede per il DLSSP oltre ad un corso di formazione di almeno 48 ore, da svolgersi entro 90 giorni dall’inizio dell’attività, anche un corso di aggiornamento quinquennale di almeno 14 ore totali.
Il rilascio dell’attestato di partecipazione è ovviamente subordinato alla frequenza di almeno il 90 per cento delle ore previste da ciascun corso ed al superamento della verifica finale effettuata tramite test o colloquio.
Nell’attesa dell’aggiornamento quinquennale, per monitorare il mantenimento delle competenze acquisite nel pregresso percorso formativo, sono consigliate verifiche annuali da svolgersi anche in modalità e-learning.
Nei corsi di aggiornamento, ovviamente non vengono trattati i contenuti già proposti nei corsi di base, ma si affrontano argomenti innovativi, applicazioni pratiche ed approfondimenti in materia tecnico-organizzativa e giuridico-normativa, sui sistemi di gestione e processi organizzativi, sulle fonti di rischio e sulle tecniche di comunicazione volte all’informazione e alla formazione dei lavoratori in tema di promozione della salute e della sicurezza nei luoghi di lavoro.
Formazione dei lavoratori
Secondo quanto previsto dal nuovo Accordo, la formazione dei lavoratori dovrà essere articolata in due step formativi differenti:una formazione generale, di almeno quattro ore, dedicata alla presentazione dei concetti generali in tema di prevenzione e sicurezza sul lavoro e una formazione specifica in relazione al rischio. Quest’ultima, per i settori rientranti nella categoria ad alto rischio come quello sanitario, deve avere una durata di almeno 12 ore ed è comunque soggetta alle ripetizioni periodiche previste al comma 6 dell’articolo 37 del D.Lgs. n. 81/08, con riferimento ai rischi individuali ai sensi dell’articolo 28.
Per il settore sanitario, è stato stabilito che la formazione dei lavoratori è obbligatoria in occasione della costituzione del rapporto di lavoro, in caso di trasferimento, di cambiamento di mansioni, introduzione di nuove attrezzature di lavoro, nuove tecnologie o sostanze pericolose. Tale obbligo è fissato anteriormente o entro 60 giorni dalla data di assunzione.
Formazione del preposto
Secondo il D.Lgs. n. 81 del 9 aprile 2008, il preposto è colui che, in ragione delle competenze professionali e nei limiti dei poteri gerarchici e funzionali adeguati alla natura dell’incarico conferitogli, sovrintende all’attività lavorativa e garantisce l’attuazione delle direttive ricevute, controllandone la corretta esecuzione da parte dei lavoratori ed esercitando un funzionale potere di iniziativa.
Essendo un lavoratore dovrà svolgere anche lui sia la formazione generale che quella specifica prevista dal settore di appartenenza, a cui però si aggiungerà un’ulteriore formazione della durata minima di otto ore in relazione ai compiti da lui esercitati in materia di salute e sicurezza. Al termine del percorso formativo è prevista una verifica di apprendimento sotto forma di test o colloquio.
Formazione dei dirigenti
La formazione dei Dirigenti, invece, sostituisce integralmente quella prevista per i lavoratori. L’accordo prevede una formazione della durata minima di 16 ore complessive suddivise in quattro moduli:
- Giuridico-Normativo
- Gestione ed Organizzazione della sicurezza
- Individuazione e valutazione dei rischi
- Comunicazione, Formazione e Consultazione dei lavoratori.
La formazione dovrà essere completata nell’arco di un anno, anche secondo le eventuali modalità definite negli accordi aziendali e adottati previa consultazione del Rappresentante dei lavoratori per la sicurezza.
Anche in questo caso è previsto un aggiornamento quinquennale di sei ore, durante le quali dovranno essere trattati argomenti in relazione ai propri compiti in materia di salute e sicurezza sul lavoro.
Considerata la complessità ma soprattutto l’importanza dell’argomento trattato, ForumECM ha selezionato alcuni esempi di corsi formativi in materia di salute e sicurezza sul lavoro. Si tratta di corsi rivolti a diverse categorie professionali perché, per parlare di sicurezza in ambito sanitario, è necessario considerare non solo i rischi convenzionali legati all’ambiente lavorativo ma soprattutto quelli specifici correlati all’attività del lavoratore.
Corsi diversi, quindi, ma aventi un obiettivo comune: la prevenzione e la sicurezza a tutela dei lavoratori e dei pazienti.
|
Protezione da Agenti Biologici in Ambiente Sanitario: prevenzione e
HC Training
|
|
HC Training
|
|
Basic Life Support and Defibrillation
Azienda Umberto I Policlinico di Roma
|
|
Formazione ed Addestramento sulla Movimentazione dei carici e dei pazienti
Azienda Umberto I Policlinico di Roma
|
29/10/2013
PRECEDENTI ARTICOLI

~
Educazione Continua in Medicina - Sito realizzato da Reflect.it
~
Educazione Continua in Medicina - Sito realizzato da Reflect.it